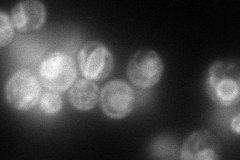
YDR236C
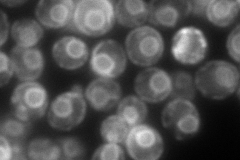
YDR236C
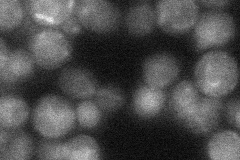
YDR236C
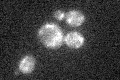
YDR236C
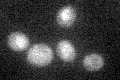
YDR236C

View description
Riboflavin kinase, phosphorylates riboflavin to form riboflavin monophosphate (FMN), which is a necessary cofactor for many enzymes; localizes to microsomes and to the mitochondrial inner membrane
Localization:
Intensity:
Fold change:
Significance:
-
C’ GFP library in SD

below threshold21.04 -
N' NOP1pr-GFP in SD
ER128.885 -
N' TEF2pr-mCherry in SD
ER208.766 -
N' NATIVEpr-GFP in SD
ambiguous22.7994 -
N' TEF2pr-VC and Cyto-VN in SD

#N/A0 -
C’ GFP library in SD+DTT

cytosol24.261.15No -
C’ GFP library in SD+H2O2
cytosol16.760.79No -
C’ GFP library in Starvation Media
cytosol21.861.03No -
C’ GFP library on the background of Pup2-DaMP

below threshold -
C’ GFP library on the background of CCT mutant

below threshold23.68231.1253No
